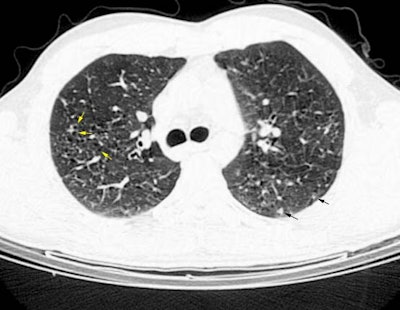
Hrct

Eosinophilic Granuloma (Langerhans Cell Histiocytosis)
The patient below was a young male smoker who complained of increasing shortness of breath. The HRCT scan revealed scattered small cysts (yellow arrows) and small peripheral nodules (black arrows). Some underlying mosaic parenchymal attenuation is also suggested. Open lung biopsy was performed and the diagnosis was eosinophilic granuloma.